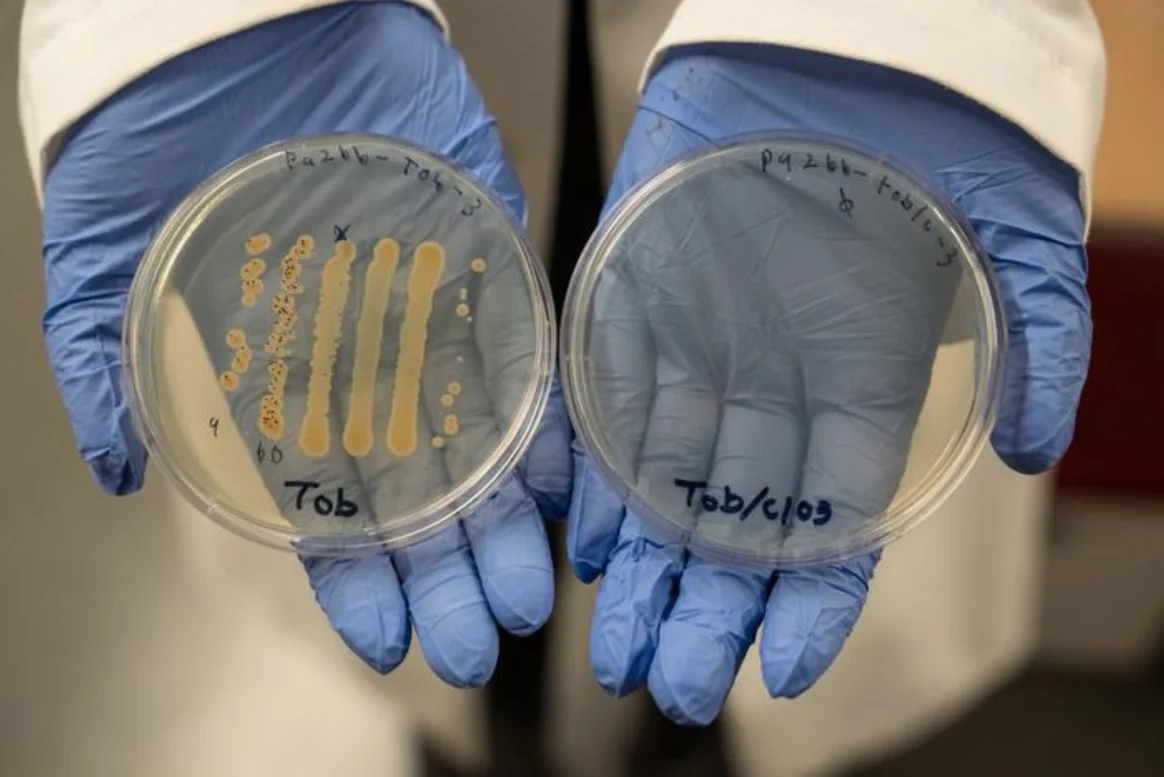

158
كشف فريق بحثي من جامعة أوريغون الأمريكية عن نهج علاجي مبتكر يضاعف فعالية المضادات الحيوية التقليدية حتى 10 آلاف مرة، ما يشكّل تقدمًا واعدًا في علاج الجروح المزمنة، خاصة قرح قدم السكري.
ويعتمد العلاج على دمج المضادات المعروفة بجرعات منخفضة من مادة الكلورات الآمنة، مما يقلل من الجرعة المطلوبة والآثار الجانبية.
وأوضحت د. ميلياني سبيرو أن الكلورات تجعل البكتيريا المقاومة، مثل الزائفة الزنجارية، أكثر حساسية للعلاج. وفق “أخبار 24”.
وشدد الباحثون رغم النتائج المشجعة، على ضرورة إجراء دراسات إضافية قبل اعتماد العلاج طبيًا، نظرًا لتعقيد الجروح المزمنة، مؤكدين أن هذا النهج يمثل خطوة واعدة في مواجهة مقاومة المضادات الحيوية بطرق أكثر ذكاء وفعالية.